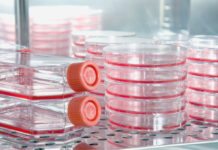
Researchers Develop Revolutionary Bioprocess Technique that Allows Continuous Production and Collection of Cells MSc Biology & Life Sciences Job Openings @ IISER Pune

Novel Drug Delivery Device for Inner Ear Disorders Developed
Novel Drug Delivery Device for Inner Ear Disorders Developed
While there continues to be a growing number of companies developing drugs to treat inner ear disorders, the...
ICAR Awards 2017 – 18 Awards of ₹ 50,000/- & 2 Awards of ₹...
ICAR Awards 2017 - 18 Awards of ₹ 50,000/- & 2 Awards of ₹ 1.00 Lakh In Cash + Citation
This call expires in :
Award...
Dissociating Side Effects of Combat Opined Addiction
Dissociating Side Effects of Combat Opined Addiction
The "wonder drug" pain medications of the mid-1990s have turned out to be a major problem – and...
New Computational Drug-Repositioning Approach Helps Repurpose Old Drugs
New Computational Drug-Repositioning Approach Helps Repurpose Old Drugs
Traditional drug development is expensive and time-consuming, taking an average of 14 years and costing >$2 billion...
Evelo Biosciences, Mayo Clinic Unite to Move Monoclonal Microbials into R&D
Mayo Clinic Unite to Move Monoclonal Microbials into R&D
Evelo Biosciences, a biotech developing therapies with specialized gut microbes is now licensing research from the Mayo...
Biotecnika Times – Newsletter 22.11.2017
Govt Job : Scientist B Post Vacant @ Central Pollution Control Board
The Central Pollution Control Board (CPCB) of India is a statutory organisation under...
Loxo Oncology, Bayer Sign $1.55B Lucrative Cancer Pact
Loxo Oncology, Bayer Sign $1.55B Lucrative Cancer Pact
Tiny US biopharmaceutical firm Loxo Oncology has now partnered up with German chemical giant Bayer to commercialize...
Researchers Develop Revolutionary Bioprocess Technique that Allows Continuous Production and Collection of Cells
Revolutionary Bioprocess Technique, Allows Continuous Production of Cells
Cell culture is a process where the cells are taken from an animal or plant and grown artificially under controlled...
Scientists “Trim-Away” Proteins to Analyse Its True Function
Scientists “Trim-Away” Proteins to Analyse Its True Function
All the cells in our body contain thousands of proteins, molecular machines which carry out almost all...
Quantum Dots to Mark Tumours
Researchers Found Quantum Dots to Mark Tumours
A simple way to harness the incredible brightness of quantum dots and realize highly sensitive molecular imaging...
Cianna Medical’s Savi Scout Tumor Locator Approved by the FDA
Cianna Medical’s Savi Scout Tumor Locator Approved by the FDA
The FDA has now cleared the world’s first non-radioactive breast tumor localization system for the...
Comprehensive Study Concludes No Link between Pesticide Glyphosate and Cancer
No Link between Pesticide Glyphosate and Cancer-Study
Glyphosate is an organophosphorus compound that interferes with the synthesis of aromatic amino acids by inhibiting the...
GM Sugar Beet Heads For EU Renewal
GM Sugar Beet Heads For EU Renewal- Latest News
The sugar beet is been genetically modified to be resistant to Monsanto’s glyphosate-based herbicide Roundup. The...
JNU Researchers Formulate Water-Based Herbicides
JNU Researchers Formulate Water-Based Herbicides
Herbicides that kill plants by inhibiting specific vital functions do not distinguish between crop plants and weeds. Such non-selective herbicides...
Kerala Government to Back Student Startups
Kerala Government to Back Student Startups- Latest News
Kerala has been single-mindedly focused on building a thriving startup ecosystem for a while now, and the Kerala Start-Up Mission (KSUM), the...